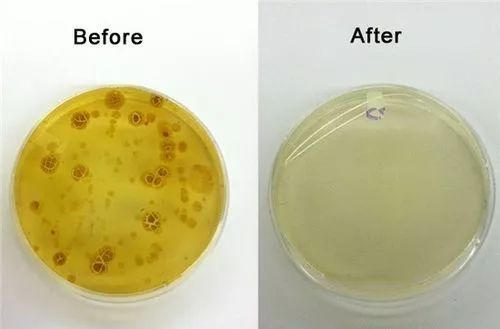
马桶清洁除味消毒去菌,马桶除菌和杀菌

出门在外的你们
一般都怎么上厕所?

emmmm,小编并不是在说废话
只是想问大家
面对公厕or宾馆厕所里的马桶
我们真的可以放心的直接用吗?
你看见的马桶是这样的

但是实际上
它的某一小块区域已经是这样的

美国耶鲁大学实验室研究发现
每平方英寸(6.4平方厘米)就积聚5295个细菌!
32%的马桶上有痢疾杆菌!
病菌在马桶上存的时间长达17天!

普通马桶尚且如此
别说清洁频率更低的公共厕所了
一份研究报告指出
将1亿个脊髓灰质炎病毒投入马桶内
测到座圈上的病毒竟有3000个
足以说明马桶的座圈简直是细菌温床

这么多数据
你害怕了吗?
不要慌,大多数人
都不可能直接坐在公共区域的马桶上

这三种如厕方式
你起码用过其中的两种

蹲在马桶上?恭喜你身手不凡
马桶垫纸? pp粘纸?
腾空如厕?坚持十分钟马步功力可达十级
并且小编在这里不得不科普
蹲在马桶上是一种非常不安全的行为!

说来说去
想要方便的上公共厕所
又不想提心吊胆担心病菌问题
只要给马桶圈消消毒就OK啦

马桶细菌杀手/酒店/公厕必备
日本kokubo小久保马桶除菌喷雾
超值两瓶装 12ml/瓶
扫码购买
日本60年口碑品牌
KOKUBO 小久保成立于 1958 年,是日本的一家产品涉猎范围极广的日用品品牌,产品设计注重细节,兼具美观和实用性。

虽然在国内没有高超的知名度,但是日本小九保的好物覆盖率非常高,几乎囊括所有居家必备品。kokubo在日本便利店都有售。

kokubo是日本市场占有率第一日用品牌。在乐天、东急、亚马逊等连续3年销售桂冠~
住酒店/短途游/所有人都能用
每次出门 尤其是景区
不是厕所难找
就是找到了又觉得太脏
拿纸擦擦好像擦不干净
蹲厕老人们又上着不方便
所以你真的需要这个马桶除菌喷雾~

经常出差在外
酒店的马桶再干净
作为更容易感染病菌 需要保护好*处私**的女性
心里也总是会有一丝丝顾虑
如果女性朋友不注意公共设施的卫生
很容易被传染上滴虫性阴道炎

每天都进行清洁的马桶,紫光灯下仍大量细菌
平常待在公司
多喝一点水就要时不时的跑厕所
而马桶坐便圈上总有那么一些“不明液体”
拿卫生纸擦擦也感觉擦不干净
这个时候一定需要KOKUBO马桶喷雾

老人,孩子的抵抗力较差
孕妈们也非常惧怕病菌
在外使用马桶更要做好清洁工作

KOKUBO马桶除菌喷雾用起来并不困难
只需要在上厕所前喷在马桶圈上
用卫生纸擦干
就能消除大部分的马桶常见菌~

15ml小小一瓶 比唇膏再长一点
放进包包非常便于携带
有洁癖的宝宝们注意了
含细菌的所有公共用品
都可以在使用之前喷一喷

共享单车的车把手也是细菌聚集地
随手消毒,无添加无色素
随着夏季高温的到来
细菌们更是到了肆意滋长的时段
人体更是最适合细菌生长的温床
一旦沾上 细菌就会迅速繁殖

KOKUBO马桶喷雾的最主要成分
就是精制水+酒精
应用离子洗净原理和天然除菌成分
隔断了与细菌直接接触的机会
除菌率高达99%
可以迅速消灭多种常见病菌
并且无香精、色素、醛类物质
消毒后的坐便圈提取物,细菌减少90%以上
喷雾喷出会有酒精的味道
每次使用时喷四五下即可
12ml的量刚好可以外出应急使用
不出门的话2支装也是相当耐用哦

生活中总需要一些呵护
KOKUBO就是为了提升你的生活幸福值
用了它
轻轻松松就能get蹲马桶的正确姿势


点击“阅读原文”或识别“文中二维码”即可完成产品购买!